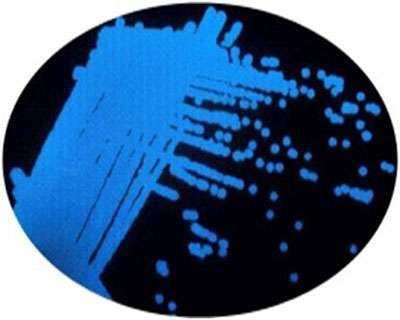

| > The Technology |  |
The PTS platform technology is designed to detect Polycyclic Aromatic Hydrocarbons (PAHs). These are the carcinogenic and widely found toxic compounds in oil spills, brownfield sites, area surrounding removed (underground) storage tanks, gasworks sites with coal tar residues, etc. The PTS has also been found to detect the wider Total Petroleum Hydrocarbons (TPHs), as well as certain pesticides and other toxic residues. |
|
 |
|
As contaminants generally bind to soil particles, extraction of contaminants from soil and other similar environments in order to test samples has always proven to be difficult. Also, since soil contaminants are usually hydrophobic, an aqueous (or water-based) extraction system does not achieve the desired extraction of contaminants from a soil sample. The PTS system has effectively and efficiently overcome these above critical challenges.
Luminescing marine bacteria (V. fischeri) are exposed to soil samples. Contaminated soil has an instant effect of a change in light emission. The purpose-built PTS instrument measures simultaneous readings from ‘control’ and ‘sample’ chambers and gives an on-the spot indication of toxicity, and an indirect measure of bioavailability and safety of the contaminating PAHs in a soil. While chemical testing provides quantitative results of the individual contaminants present in soil, such tests alone miss out the synergistic effect of the presence of two or more contaminants that can yield a toxic effect. The PTS technology platform provides a complete picture of toxicity, and whether used alone or in conjunction with chemical testing, such results can contribute to better remediation management and cost-saving decisions. 
Data from the PTS including that from the integrated GPS, in combination with commercial-off-the-shelf GIS (Geographical Information Systems) software, can be used to produce toxicity maps.
Using its specialist and relevant technology expertise, the 52 BioTechnology Ltd team integrates client feedback to continue working to upgrade and further enhance the PTS platform technology. |
|